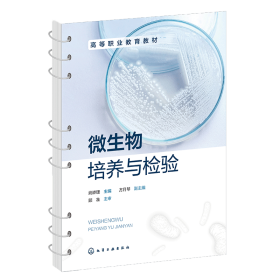

塑料 电影明星插页空白日记本 32k150页,柳荻,石可,许志威,方舒,汪明荃,姚晨牧,王琴宝,达式常,韩月乔,付艺伟,李媛,盖莉莉,庞敏,李静莉,丁岚,张文娟等(封皮较紧,没插上) ——n3
¥35.00 90
岁月读享 2022-04-05

嵊县文史资料(8)[史牛:全面认识嵊县辛亥志士的历史作用。钱方来:蔡元培在嵊县时期的教育思想与社会思想。丁宗文:嵊县辛亥革命时期的教育。袁六桥:维新运动与学堂、留学生、武备生
¥36.00 85
漫步书林 2015-12-19

中国美术名家作品集:贾宝珉沈鹏申西岚尚涛李忠纯邹文正曹德兆贾宝珉蔡天涛吴山明陈祖煌郭志光王祖铭桑作凯杨天序张自生刘大为康庄方国兴张改琴冯国伟韩云浪孙戈吴团良顾庆伟汉风黎柱成姚叶红等 精8开404页
¥36.00 100
市中区宜枫书店 2025-04-14

安庆掌故(夏天润火攻制造局。韩家铭讨伐袁世凯。张廷玉轶事。方苞狱中读书。姚鼐的文德。“豆腐总督”汪志伊。姚莹卖字。状元龙汝言。郝金官倾囊救灾民。石达开致书汤贻汾。英王和英王娘。 等
¥36.00 85
漫步书林 2023-06-28

中国美术名家作品集 贾宝珉沈鹏申西岚尚涛李忠纯邹文正曹德兆贾宝珉蔡天涛吴山明陈祖煌郭志光王祖铭桑作凯杨天序张自生刘大为康庄方国兴张改琴冯国伟韩云浪孙戈吴团良顾庆伟汉风黎柱成姚叶红等 精8开404页
¥36.00 100
市中区宜枫书店 2015-09-10

塑料 电影明星插页空白日记本 32k150页,柳荻,石可,许志威,方舒,汪明荃,姚晨牧,王琴宝,达式常,韩月乔,付艺伟,李媛,盖莉莉,庞敏,李静莉,丁岚,张文娟等——n3
¥40.00 90
岁月读享 2022-04-05

1996年9月15日,中原书画报。老年国画家谢传良,大连。刘炳森,贺成,苗德文,柴建方,齐良迟,雷正民,刘治国,王衡鉴,王冠,黄尹良,金明华,吴文倩,阮诚,王挥春,姚小尧。解传良艺术简历。合售
¥40.00 60
宇宙风 2025-06-30